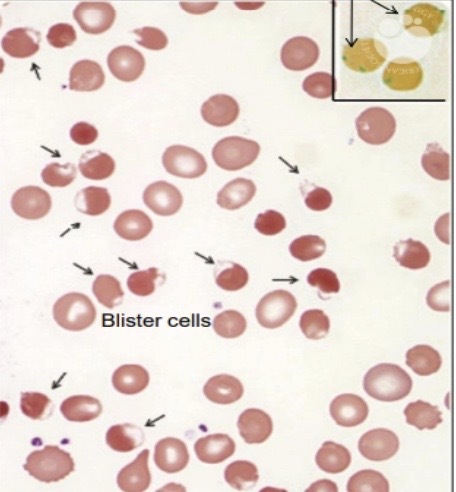

sites of hemolysis
- intravascular
- extravascular
give disease examples of intravascular hemolysis
- hereditary spherocytosis
- G6PD def.
- SCD , thalassemia
mention 2 integral RBC membrane proteins
BAND 3 , glycophorins
mention 2 peripheral RBC membrane proteins
spectrin , ankyrin
cause of hereditary spherocytosis
def. or functional abnormalities in RBcC membrane proteins
genetic predisposition of hereditary spherocytosis
autosomal dominant
severe forms : autosomal recessive
function of G6PD
synthesis of NADPH & GSH
Function of GSH
RBC protection against oxidant damage
you will confirm your G6PD def. Diagnosis if you see these in blood smear
- heinz bodies
- blister cells
- bite cells , spherocytes
point mutation in beta globin gene will cause
sickle cell disease
levels of beta globin in beta thalassemia
Decreased
Levels of alpha globin in beta thalassemia
Increased
in alpha thalassemia , HbH precipitates as
inclusion bodies
when antibodies inhibit ADAMTS13 , Pts WILL DEVELOP
thrombotic thrombocytopenic purpura


